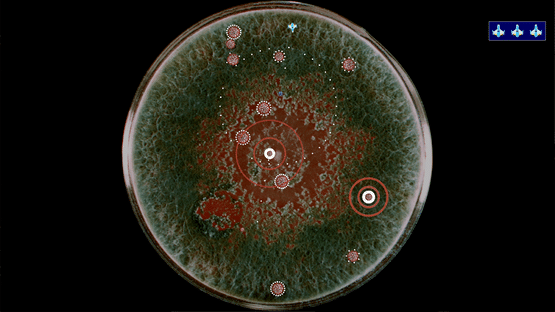
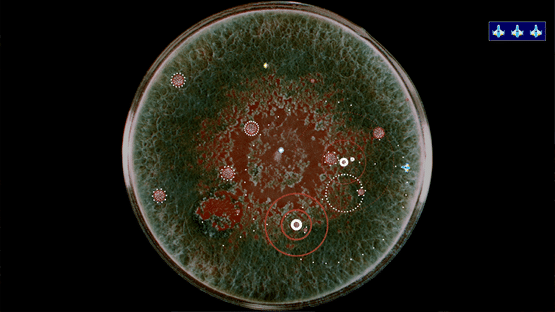

Coronavirus: Nano Force (2020)
A fast-paced arcade shooter where you pilot a nano-ship in the fight against the Coronavirus. Grab powerups to upgrade your weapons and eliminate the virus infection.
- Release Date: June 25, 2020
- Developer: Daniel Snow
Screenshots
Related Games
-
Havocado
2019
-
Rogue Heist
2019
-
Apsulov: End of Gods
2019
-
GentleMoon 2
2016
-
Knight Brawl
2019
-
Park Bound
2017
-
Torchlight III
2020
-
Dude Simulator
2017
-
Tanzia
2018
-
Rico
2019